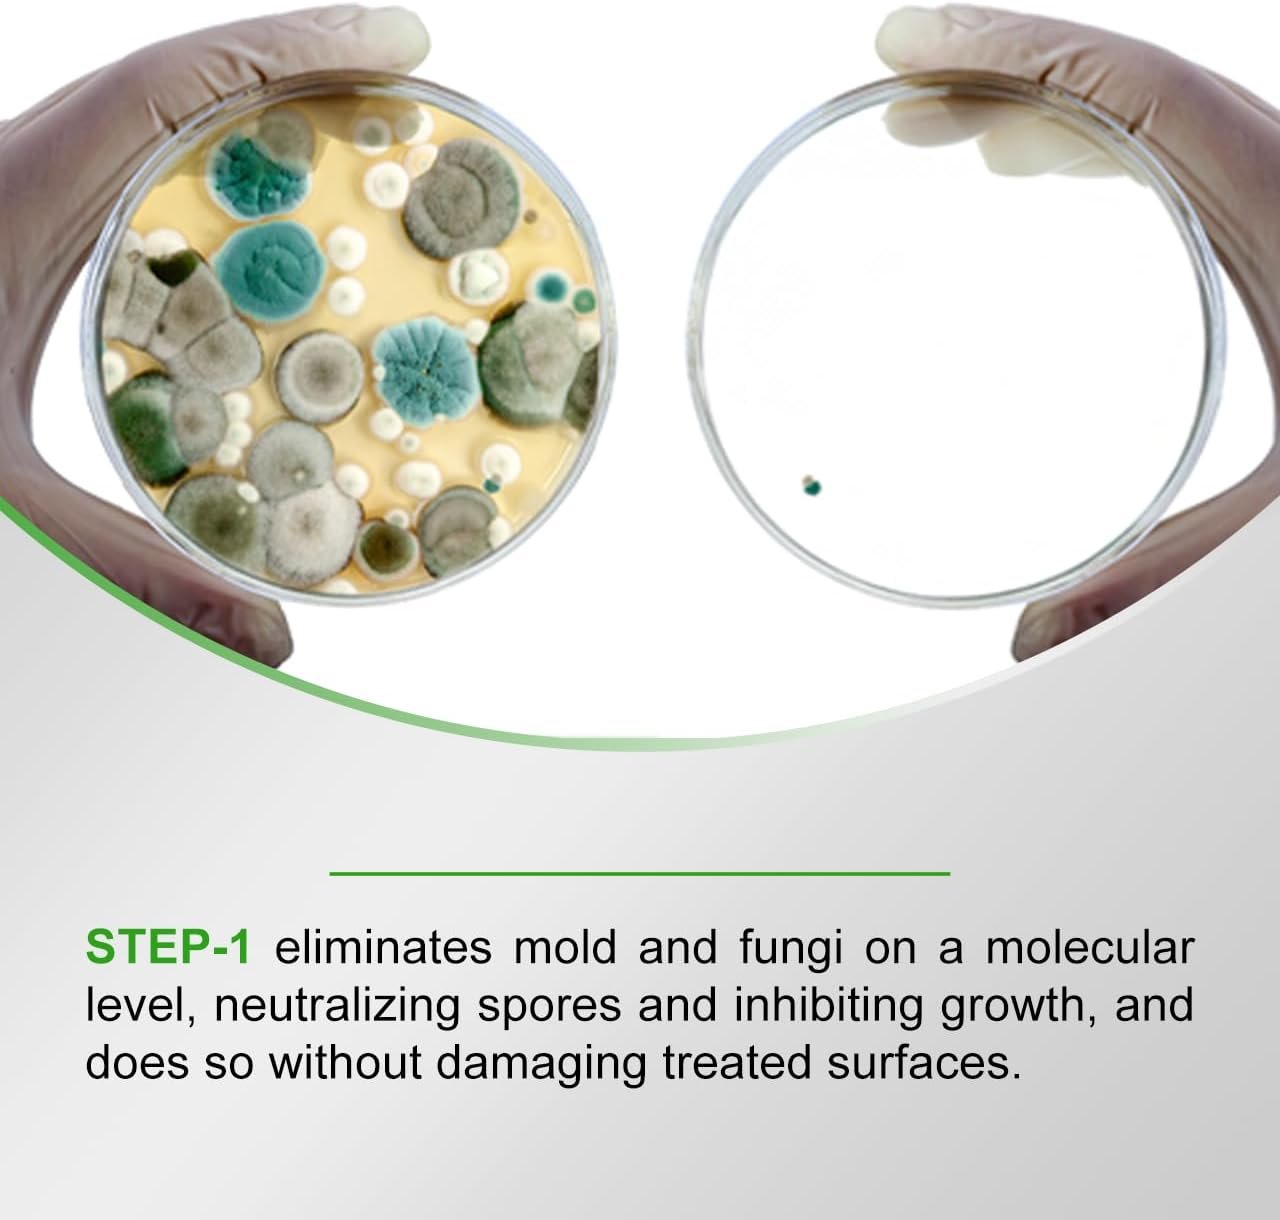

Price: $79.00
(as of Nov 23, 2025 12:57:46 UTC – Details)
From the brand


















Product Dimensions : 5.5 x 7.5 x 12 inches; 8 Pounds
Item model number : PCS-G28
Date First Available : May 6, 2024
Manufacturer : PermaSafe HVAC Solutions
ASIN : B0D94SQFPL
Best Sellers Rank: #148,719 in Health & Household (See Top 100 in Health & Household) #62 in Household Mold & Mildew Removers
Customer Reviews: 4.3 4.3 out of 5 stars 21 ratings var dpAcrHasRegisteredArcLinkClickAction; P.when(‘A’, ‘ready’).execute(function(A) { if (dpAcrHasRegisteredArcLinkClickAction !== true) { dpAcrHasRegisteredArcLinkClickAction = true; A.declarative( ‘acrLink-click-metrics’, ‘click’, { “allowLinkDefault”: true }, function (event) { if (window.ue) { ue.count(“acrLinkClickCount”, (ue.count(“acrLinkClickCount”) || 0) + 1); } } ); } }); P.when(‘A’, ‘cf’).execute(function(A) { A.declarative(‘acrStarsLink-click-metrics’, ‘click’, { “allowLinkDefault” : true }, function(event){ if(window.ue) { ue.count(“acrStarsLinkWithPopoverClickCount”, (ue.count(“acrStarsLinkWithPopoverClickCount”) || 0) + 1); } }); });
STEP-1 Penetrates surfaces to destroy mold, mildew, fungi, and other microorganisms at their roots
Triple active ingredients deliver maximum germicidal cleaning, and more, with minimum effort.
Eliminates HVAC System and ductwork odors at their source, and helps prevent their return.
STEP-2 Creates a durable antimicrobial barrier on treated HVAC System components and air ducts.
Helps keep treated surfaces bacteria, mold, fungi and algae free for up to 3 months.
Waterproof, weatherproof, won’t wash or wear off with normal use, cleaning, or maintenance.

![[SKIN&LAB] Retinol Lifting Roller Cream with Massage applicator, Vegan Anti Aging Face and Neck Cream for Reduce Wrinkles and Fine Line, For Face, Neck, Décolleté Wrinkle Care, 1.69 fl. oz. [SKIN&LAB] Retinol Lifting Roller Cream with Massage applicator, Vegan Anti Aging Face and Neck Cream for Reduce Wrinkles and Fine Line, For Face, Neck, Décolleté Wrinkle Care, 1.69 fl. oz.](https://m.media-amazon.com/images/I/41jBaNLgljL._SL1000_.jpg)
![[Timer] 2 Pack Valentines Day Decorations Pink & Red Hearts Lights, Valentine Day Garland with Light Total 13Ft 40LED Beads Hearts String Light Battery Operated Valentines Day Lights for Home Bedroom [Timer] 2 Pack Valentines Day Decorations Pink & Red Hearts Lights, Valentine Day Garland with Light Total 13Ft 40LED Beads Hearts String Light Battery Operated Valentines Day Lights for Home Bedroom](https://m.media-amazon.com/images/I/81kfJBvD7xL._AC_SX679_.jpg)





Reviews
Clear filtersThere are no reviews yet.